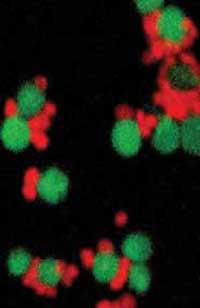

Nanoarchaeum equitans, primer miembro de un nuevo grupo de seres vivos
Estos seres han sido encontrados por un grupo de científicos que estudian las chimeneas hidrotermales situadas en el fondo marino de la costa islandesa. Las chimeneas se producen por el agua y los gases que salen del interior del suelo a una enorme presión. Hace treinta años, los científicos descubrieron una fauna más rica de lo esperado en esta zona extrema.
En esta ocasión, el equipo de científicos que estudia los microorganismos de las chimeneas de la costa islandesa ha realizado por casualidad un descubrimiento más grande de lo esperado.
Al tomar y analizar muestras de rocas y gravas en las proximidades de las chimeneas, se han dado cuenta de que junto con las nuevas especies del género Igniococcus, que forma parte del grupo de arqueólogos, existen otras estructuras esféricas más pequeñas. Los nuevos seres tienen un diámetro de 400 nm y se han visto con teñido in situ con ADN propio. Al identificar una molécula de ARN del ser se dedujo que estaba relacionada con los arqueos. Sin embargo, no tiene mucho que ver con los arqueólogos que se conocen hasta ahora. Así que han formado un nuevo equipo, los nanoarqueos.

Como su nombre indica son microorganismos muy pequeños con un diminuto genoma de 500 kilobases. Sólo los que conviven con Igniococcus son conocidos y la relación entre ambos no está clara.
Tampoco saben el origen de los nanoarqueólogos. Algunos creen que puede ser un tipo de célula intermedia entre las primeras células que aparecieron en la Tierra y las actuales, es decir, una forma primitiva que hasta ahora no se había detectado. Otros consideran que una forma pequeña y simple puede ser la influencia de la evolución, es decir, un ser que partiendo de unos arqueos más complejos, debido a sus condiciones de vida, ha simplificado su metabolismo debido a la evolución.
Buletina
Bidali zure helbide elektronikoa eta jaso asteroko buletina zure sarrera-ontzian














